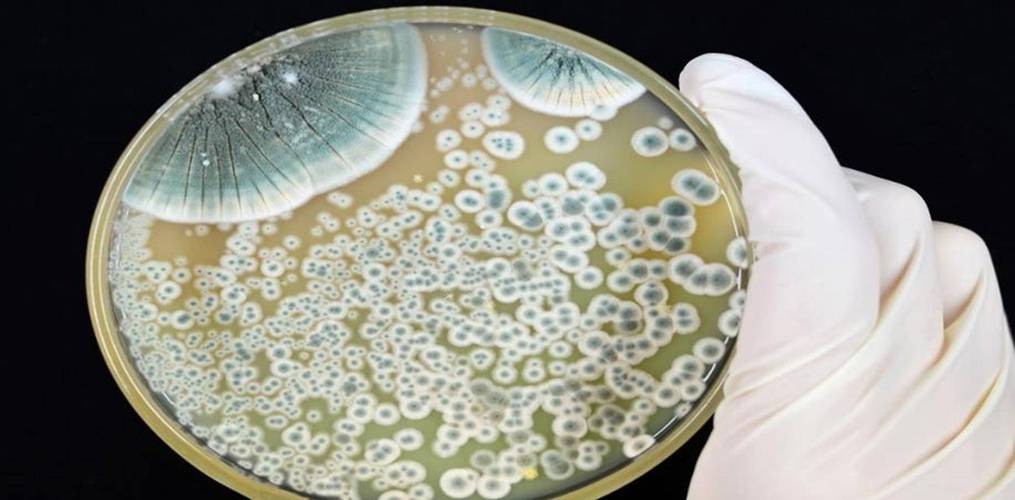
神医在世，亚历山大·弗莱明创造出神奇药，拯救了上万人的性命

文 | 大王体坛
编辑 | 大王体坛
●○前言○●
亚历山大·弗莱明(Alexander Fleming,1881年8月6日-1955年3月11日)是苏格兰微生物学家和医生,以他对抗生素的发现而闻名于世,他的发现不仅挽救了无数生命,还对医学和科学产生了深远的影响。
●○生平背景○●
亚历山大·弗莱明于1881年8月6日出生在苏格兰的一个农村地区,他是家中四个孩子中的一个。

由于家庭贫困,他的父母努力供他接受教育,培养他对学习的兴趣。弗莱明在农村学校接受了初等教育后,被送往伦敦学习进一步的知识。
在1895年,弗莱明进入了伦敦大学学院(University College London),他学习到了物理学、化学和细菌学等学科。
在大学期间,他表现出对细菌学的特别兴趣,并在该领域的研究中取得了成绩。弗莱明于1901年获得了医学学位,并开始在伦敦的多家医院进行临床实习和培训。
1906年,弗莱明获得了皇家外科医生学院(Royal College of Surgeons)的会员资格,并于1908年成为英国皇家内科医师学院(Royal College of Physicians)的会员。

随后,他开始在圣玛丽医院(St. Mary's Hospital)担任临床助理,并在医院内设立了自己的实验室,从事细菌学和免疫学的研究。
1915年,弗莱明加入了*队军**,参加了第一次世界大战,担任了军医,在*队军**的工作中,他与战地感染病症和伤口感染进行了紧密的接触,这进一步加深了他对感染病理的理解。
战后,他回到圣玛丽医院继续他的研究工作,同时也开始在伦敦大学学院担任教职,弗莱明在职业生涯中取得了广泛的成就,他的研究涉及细菌学、病理学和免疫学等多个领域。
在1921年,他成为伦敦大学学院的细菌学教授,并一直担任该职位直到1948年,在他的教职生涯中,他指导了许多学生和年轻的研究人员,影响了一代又一代的科学家。

亚历山大·弗莱明的生平和教育背景是他成为杰出的微生物学家和医生的基础,从早年贫困的农村生活到伦敦大学学院的学习,再到他在医学和细菌学领域的卓越成就,弗莱明的教育背景为他的科学探索奠定了坚实的基础。
●○对抗生素的突破性发现○●
抗生素的突破性发现与亚历山大·弗莱明密切相关,1928年的一个偶然事件成为了抗生素的发现之路。
1928年9月3日,弗莱明在伦敦圣玛丽医院的实验室进行细菌培养实验。在这个普通的日子里,他正在研究葡萄球菌的特性。
然而,他注意到实验室里的一盘葡萄球菌细菌培养皿出现了意外的情况,在实验结束后,他注意到一块不起眼的污点,在这块污点周围的细菌却没有像其他区域一样繁殖和生长。

好奇心驱使下,弗莱明仔细观察了这个现象,他发现污点是由一种绿色的霉菌所引起的,后来确认为青霉菌(Penicillium notatum)。
更令他惊讶的是,周围细菌在霉菌的附近竟然纷纷死亡,形成了一个清晰的无菌区域。
弗莱明迅速开始对这一现象展开深入研究,他收集了大量的青霉菌,并将其提取出的液体用于不同类型的细菌培养。
结果都显示这种液体都有抑制细菌生长的效果,他意识到这个发现可能是有史以来最重要的医学发现之一。
他将这种液体称为"青霉素(Penicillin)",这个名字来自于霉菌的学名,他在一篇名为《青霉素的抗菌作用:新一类抑制细菌的物质》的论文中首次发表了他的发现。

然而,由于当时实验条件和技术有限,他并没有能够从青霉素中提取纯净的药物,因此他并没有能够进一步开发或广泛应用这一发现。
虽然弗莱明并未对抗生素的开发作出更进一步的贡献,但他的发现为后来的研究奠定了基础。
在随后的几十年里,其他科学家继续探索抗生素的潜力,并最终成功地分离出纯净的青霉素,将其应用于医学领域。
1945年,弗莱明与霍华德·弗洛里(Howard Florey)和恩斯特·鲁丁(Ernst Boris Chain)共同获得诺贝尔生理学或医学奖,以表彰他们在抗生素的发现与研究方面的杰出贡献。
青霉素的发现开启了抗生素时代,革命性地改变了医学和生物学领域,它为感染性疾病的治疗提供了有效的解决方案,挽救了数以百万计的生命,并为现代医学的发展打下了坚实基础,抗生素的应用在医学史上被誉为一次革命,并且成为现代医学的一个里程碑。

●○青霉素的研究与应用○●
青霉素的研究与应用经历了多年的艰苦探索和努力,虽然亚历山大·弗莱明首次发现了青霉素,但由于当时实验条件的限制,他无法从霉菌中提取纯净的药物。
然而,这一发现激发了其他科学家的兴趣,特别是在二战期间,青霉素在治疗士兵的伤口感染中取得了显著的成功,进而推动了抗生素研究和应用的进展。
在弗莱明发现青霉素后,埃尔温·查尔斯(Ernst Boris Chain)和霍华德·弗洛里(Howard Florey)等科学家在二战期间进行了关键性的研究工作,成功地从青霉素中分离出纯净的药物。
他们采用了多种提取和纯化技术,最终成功地得到了高纯度的青霉素,并证明其对细菌感染具有显著的杀菌效果。

在二战期间,青霉素被首次广泛应用于战地伤员的治疗中。英国和美国的*队军**迅速采用了青霉素,用于治疗伤口感染和其他感染病例。
在战场上,青霉素的效果显著,挽救了大量的生命,使得受伤士兵的康复速度大幅加快。
由于青霉素在治疗战伤中的巨大成功,迫切需要大规模生产这种重要的药物,在战争期间,英国和美国的科学家们开展了大规模生产青霉素的研究,开发了有效的生产方法,确保足够的药物供应。
随着青霉素的广泛应用,抗生素革命拉开了序幕,其他抗生素,如链霉素、四环素和氨苄西林等,也相继被发现和开发。
这些抗生素的发现和应用使得人类能够有效地治疗许多感染性疾病,从而大大提高了生存率和生活质量。

随着抗生素的广泛应用,出现了抗生素耐药性的问题,由于过度使用和滥用抗生素,细菌开始产生耐药性,导致某些感染变得难以治疗。
这对全球公共卫生构成了严重威胁,科学家和医生都在寻求解决方案,以确保抗生素的可持续使用。
青霉素的研究与应用是医学史上的一大突破。它改变了传统的感染性疾病治疗方式,挽救了大量生命,同时也催生了抗生素时代。
然而,抗生素耐药性的问题需要持续关注和努力解决。因此,合理使用和管理抗生素是保护这一珍贵资源的关键措施。
●○抗生素革命与现代医学的演变○●
抗生素革命是现代医学的一个里程碑性事件,对医学的演变产生了深远的影响。
抗生素的发现和广泛应用使得感染病治疗发生了革命性的变化,过去,许多感染性疾病被认为是致命的,例如细菌性肺炎、肺结核、脑膜炎等。
然而,抗生素的出现使得这些疾病可以通过简单有效的药物治疗进行控制,使许多曾经致命的疾病变得可以治愈。
在抗生素出现之前,手术和外科治疗的风险非常高,因为术后感染是一个严重的问题。
但随着抗生素的应用,术前和术后预防性使用抗生素大大降低了手术感染的发生率,使得手术和外科治疗的安全性大幅提高。

抗生素的广泛应用显著降低了婴幼儿和儿童的死亡率,过去,许多常见的感染性疾病如脑膜炎和肺炎在儿童中是致命的,抗生素的使用使得这些疾病可以及时得到治疗,挽救了无数儿童的生命。
抗生素的应用对全球卫生产生了巨大的积极影响,许多传染病得以控制,大规模疫苗接种计划的实施也得到了有效支持,使得公共卫生得到了长足的进步。
尽管抗生素革命改变了医学,但滥用和不合理使用抗生素也导致了抗生素耐药性的迅速发展,耐药性细菌的出现威胁着人类健康,需要全球合作来防止和控制耐药性的蔓延。
由于抗生素耐药性的威胁,科学家们在不断努力寻找新型抗生素,虽然抗生素的研发非常复杂和耗时,但仍有新型抗生素不断被发现和研发,为医学提供了更多治疗选择。

抗生素革命是现代医学的重要里程碑,极大地改变了人类对待感染性疾病的方式,抗生素的发现和应用使得许多过去致命的疾病变得可以治愈,大幅提高了生命质量和预期寿命。
然而,抗生素耐药性的挑战也需要引起重视,全球合作来防止和控制耐药性的蔓延是现代医学面临的重要课题。
只有在科学家、医生和公众共同努力下,抗生素才能继续为人类健康发挥重要作用。
●○弗莱明对医学与科学的遗产○●
亚历山大·弗莱明对医学与科学的遗产是无可估量的,他的发现和贡献对人类健康和科学研究产生了深远的影响。

弗莱明的最重要的贡献之一就是青霉素的发现,这是医学史上的一大突破,改变了感染性疾病的治疗方式,挽救了数以百万计的生命,青霉素的发现开启了抗生素时代,使得人类能够有效地治疗许多细菌感染。
弗莱明的发现激发了后续科学家对抗生素的研究兴趣,他的工作为后来的研究提供了启示,推动了抗生素的研发和开发。
随后出现的许多其他抗生素的发现和应用,进一步拓展了医学的治疗领域,弗莱明因其对抗生素的发现和研究而获得了1945年的诺贝尔生理学或医学奖。
这一荣誉不仅表彰了他个人的杰出贡献,也为抗生素研究和应用在全球范围内获得了更多的关注和支持。

弗莱明在伦敦大学学院担任教职期间,指导了许多学生和年轻的研究人员,他对科学的热情和奉献精神,激励着后来的科学家继续探索和创新,他的学生们成为了许多领域的杰出科学家,进一步扩大了他的科学遗产。
抗生素的应用使得许多感染性疾病得到控制,从而显著提高了公共卫生水平,弗莱明的发现为公共卫生的改进和全球健康的促进做出了重要贡献。
亚历山大·弗莱明作为抗生素的发现者,其对医学与科学的遗产是巨大而持久的,他的发现革命性地改变了感染性疾病的治疗方式,拯救了数以百万计的生命,并为后来的科学家提供了启示和方向。
他的遗产将永远铭记在医学史和科学史上,他的成就和影响将激励着未来科学家继续追求知识和创新,为人类健康和福祉做出更多的贡献。
●○结论○●
亚历山大·弗莱明的发现革命性地改变了医学与科学领域,其对人类健康和全球公共卫生产生了深远的影响。

抗生素的发现开启了抗生素时代,挽救了数以百万计的生命,使得许多过去致命的感染性疾病变得可以治愈。
弗莱明的贡献不仅在于他本人的发现,还在于他激发了后续科学家对抗生素研究的兴趣,推动了抗生素的研发和应用。
抗生素的广泛应用提高了手术和外科治疗的安全性,降低了感染的风险,也显著改善了儿童和婴幼儿的生存率。
此外,抗生素的发现也促进了现代医学的发展,为其他药物的研发和治疗方法的改进提供了经验和启示。

然而,抗生素的滥用和不合理使用也导致了抗生素耐药性的威胁,这是当今医学面临的严峻挑战之一,因此,合理使用抗生素,避免滥用和过度使用,是保护这一珍贵资源的关键。
亚历山大·弗莱明的发现和贡献将永远铭记在医学史和科学史上。他的遗产激励着后代科学家继续追求知识和创新,不断探索新的治疗方法和药物,为人类健康和福祉做出更多的贡献。
我们应该珍惜抗生素的作用,同时意识到抗生素耐药性的问题,并共同努力寻求解决方案,确保抗生素在未来能继续发挥其重要的作用,造福人类。